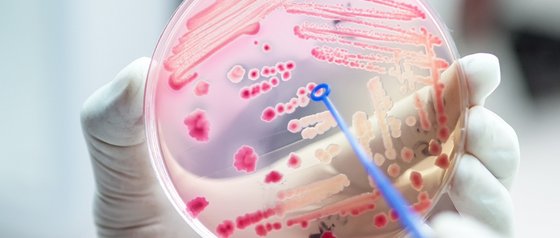

Our products
Welcome to Satino
A brand that creates modern, comprehensive hygiene solutions and also fulfils high expectations for washrooms and hygiene. We set new standards - through innovation, customised solutions and industry-specific hygiene expertise.
From sanitary paper to dispenser systems, from disinfectants and soaps to washroom accessories - everything from a single source: our innovative products impress with their cost-effectiveness and sustainability. They impress with their design and convenience. And their development is based on scientific findings. This makes your everyday hygiene even safer.
We think in detail and keep an eye on the big picture. This is how we ensure a high-quality, sustainable hygiene experience.
Coding
Use the codes to find the right Satino product for your Satino dispenser at all times - and vice versa. No long searches or incorrect purchases. For more efficiency in the ordering process. This makes the re-order process easier for both partners.
The ‘silent pandemic’ in the washroom: simple measures for health care
Bacteria, germs and infections have always been a health risk. The greatest challenge today is that…
Focus on sustainability – the WEPA Report 2024 is here!
How can we shape a sustainable future for hygiene together? The new Sustainability Report 2024…